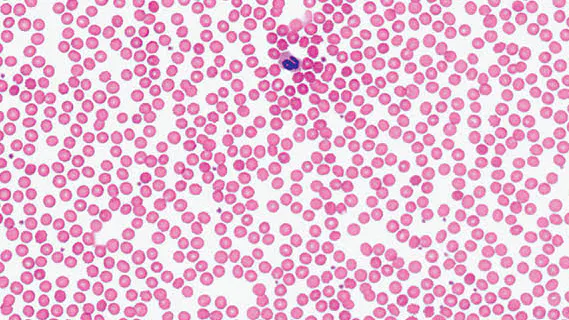
5番目のメイン画像

活動報告はまだありません。





現在の支援総額
5,000円
目標金額は3,000,000円
支援者数
1人
募集終了まで残り
終了
このプロジェクトは、2022/03/30に募集を開始し、 1人の支援により 5,000円の資金を集め、 2022/05/23に募集を終了しました

現在の支援総額
5,000円
0%達成
目標金額3,000,000円
支援者数1人
このプロジェクトは、2022/03/30に募集を開始し、 1人の支援により 5,000円の資金を集め、 2022/05/23に募集を終了しました
活動報告はまだありません。